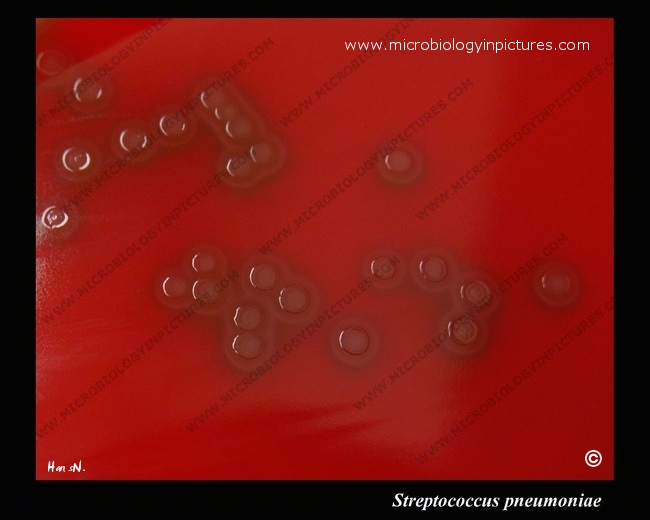

Zones of alpha-hemolysis around colonies of Streptococcus pneumoniae. Alpha-hemolytic colonies with depressions in their centers are characteristic of pneumococci. The term alpha-hemolysis was introduced by Brown in 1919 to describe slight hemolysis with greening around some streptococcal colonies cultivated on agar plates with blood.
Cultivated on Columbia sheep blood agar aerobically, 5% carbon dioxide, overnight.